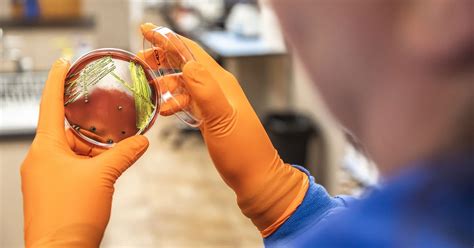

PSSI Latest Updates And Breaking News
PSSI Latest Updates and Breaking News
Hey guys, let’s dive into the absolute latest buzz surrounding PSSI! We all know how crucial it is to stay in the loop with football news, and when it comes to the Indonesian football scene, PSSI (Football Association of Indonesia) is the main stage. This isn’t just about game scores, people; it’s about the future of the sport in our beloved nation. We’re talking about everything from player development and league integrity to international competitions and the overall health of Indonesian football. So, grab your favorite snacks, settle in, and let’s break down what’s been making waves. We’ll be covering the juiciest PSSI breaking news, giving you the lowdown on decisions that shape our players, our teams, and our dreams on the pitch. Get ready for some insightful analysis and maybe a few surprises along the way. This is where you’ll find the most current and relevant information, presented in a way that’s easy to digest and keeps you totally hooked. We’re committed to bringing you the most accurate and up-to-date information, because we know how passionate you are about Indonesian football. So, whether you’re a die-hard fan, a casual observer, or someone just curious about the sport, this is your go-to spot for everything PSSI. We aim to demystify the world of football administration and bring you closer to the action, the decisions, and the people who make it all happen. Stay tuned, because the game is always evolving, and so is the news!
Table of Contents
Key Decisions and Their Impact
So, what’s been happening lately in the PSSI universe? A lot, guys, a whole lot! One of the most talked-about PSSI breaking news items has been the recent policy changes regarding naturalized players . Now, this is a big one, and it’s sparked a ton of debate. On one hand, you have the argument that bringing in foreign talent can elevate the level of competition and provide valuable experience for our local players. It’s like giving our national team a serious boost, right? But then, there’s the other side of the coin: the concern that it might stifle the growth of homegrown talent. Are we giving enough opportunities to the young Indonesian stars who have been grinding it out? This is a delicate balancing act, and PSSI has been wrestling with it. The decisions made here have ripple effects throughout the entire football ecosystem. Think about it: it affects coaching strategies, youth academy development, and even the fan’s perception of the national team. We’re talking about players who might have Indonesian heritage but grew up elsewhere, and the criteria for them joining our squad. It’s not as simple as just picking players; there are regulations, eligibility rules, and the overall vision for the national team’s future. We’ve seen coaches and former players weigh in, each with their own valid points. Some argue that a mix of experienced foreign-based players and rising local stars is the winning formula. Others insist that the focus should be purely on nurturing talent from within. It’s a constant conversation, and PSSI’s stance on this has been evolving. Keeping up with these PSSI breaking news updates is essential for understanding the strategic direction the association is taking. It’s not just about who’s playing; it’s about why they’re playing and what it means for the long-term development of Indonesian football. We need to consider the impact on clubs as well, as they are the foundation upon which the national team is built. The debate is fierce, the stakes are high, and the decisions made now will undoubtedly shape the future of Indonesian football for years to come. We’ll keep you updated on any new developments in this crucial area.
League Reforms and Competitions
Another area where we’ve seen a lot of PSSI breaking news is in the reforms of our domestic leagues . Our leagues are the bedrock of Indonesian football, and ensuring they are competitive, fair, and exciting is paramount. We’re talking about the Liga 1, Liga 2, and beyond. PSSI has been working tirelessly to address issues that have plagued our leagues in the past, such as match-fixing, financial instability, and inconsistent officiating. The goal is to create a more professional and attractive product for fans, sponsors, and players alike. This often involves restructuring the league format, implementing stricter regulations, and investing in infrastructure and technology. For example, there have been discussions and even implementation of VAR (Video Assistant Referee) in certain matches, a move that aims to improve the accuracy of refereeing decisions and reduce controversial calls. This, of course, comes with its own set of challenges, including the cost of implementation and the training of personnel. Furthermore, PSSI has been looking at ways to enhance the financial health of clubs, perhaps through better revenue-sharing models, increased sponsorship opportunities, and more transparent financial reporting. The integrity of the league is key; if fans don’t trust the results, they won’t tune in. This is why monitoring PSSI breaking news for updates on league governance and disciplinary actions is so important. We’ve also seen initiatives to improve the quality of pitches and training facilities, which directly impacts the quality of play. A better league means better players, and better players mean a stronger national team. It’s all interconnected, guys. The PSSI breaking news on league reforms often highlights a commitment to modernization and a desire to align Indonesian football with international best practices. It’s not just about playing the game; it’s about running the game effectively and efficiently. We’re seeing efforts to create a more sustainable footballing environment where clubs can thrive and players can develop their careers with confidence. This includes discussions about promotion and relegation systems, playoff formats, and even the calendar of matches to avoid fixture congestion and ensure player welfare. The ultimate aim is to build a league system that is not only exciting for fans but also a true engine for talent development and national pride. These reforms are crucial for the long-term health and success of Indonesian football, and we’ll be keeping a close eye on all the PSSI breaking news related to these significant developments.
National Team Strategies and Performance
Now, let’s talk about the team we all cheer for: the Indonesian national team! Any PSSI breaking news concerning our Garuda squad always gets us talking. Recent developments have focused on strategic planning for upcoming tournaments, like the AFF Championship and World Cup qualifiers. This isn’t just about picking the best players available; it’s about building a cohesive unit with a clear playing style and tactical approach. Coaches are constantly evaluating player performance, identifying areas for improvement, and devising strategies to counter opponents. We’ve seen shifts in coaching staff, with new philosophies being introduced, aiming to inject fresh energy and tactical acumen into the team. The PSSI breaking news in this sector often touches upon the selection process, training camps, and friendly matches designed to test the squad’s chemistry and readiness. It’s a high-pressure environment, and the team’s performance directly reflects the effectiveness of the planning and development undertaken by PSSI. Fans are always eager to see how the team performs, and there’s a lot of discussion about the team’s strengths and weaknesses. Are we scoring enough goals? Can we defend effectively? What’s our midfield control like? These are questions that PSSI and the coaching staff are constantly trying to answer. Furthermore, the integration of newly naturalized players, as mentioned earlier, is a significant part of the national team strategy. The goal is to create a competitive squad that can challenge not only regionally but also on the international stage. Staying updated on PSSI breaking news is key to understanding the long-term vision for the national team. Are we focusing on youth development to ensure a pipeline of talent? Are we investing in sports science and analytics to gain a competitive edge? These are critical questions that PSSI is addressing. The performance of the national team is often seen as a barometer for the overall health of Indonesian football, and there’s immense pressure to succeed. We’re talking about national pride, and the players and management feel that keenly. The PSSI breaking news often highlights initiatives aimed at improving player welfare, providing better support systems, and ensuring that the team is mentally and physically prepared for the challenges ahead. It’s a continuous cycle of evaluation, adaptation, and striving for excellence. The ultimate objective is clear: to see the Indonesian national team achieve greater success on the global stage, and all these strategic moves by PSSI are geared towards that ambitious goal. We’ll be sure to report on any significant PSSI breaking news concerning the national team’s preparations and future outlook.
Challenges and Future Outlook
Looking ahead, it’s clear that PSSI faces a landscape filled with both opportunities and challenges. The PSSI breaking news often reflects the ongoing efforts to overcome persistent issues while capitalizing on the growing passion for football in Indonesia. One of the major hurdles has been improving the infrastructure and facilities across the country. While there have been strides made, particularly in major urban centers, many regions still lack proper training grounds and stadiums that meet international standards. This directly impacts player development and the ability to host significant tournaments. PSSI is actively seeking partnerships and funding to address these infrastructural gaps, as it’s fundamental for growth. Another critical challenge is maintaining the integrity of the game . Issues like match-fixing and corruption have, in the past, tarnished the reputation of Indonesian football. PSSI has been implementing stricter oversight, transparent reporting mechanisms, and robust disciplinary actions to combat these threats. The commitment to clean football is non-negotiable for building trust with fans and stakeholders. Fan engagement and support are also crucial elements. With a massive population that loves football, PSSI aims to harness this passion more effectively. This includes improving the match-day experience, ensuring affordable ticket prices, and fostering a positive and respectful fan culture. Social media and digital platforms are increasingly being used to connect with fans, share information, and gather feedback, making the latest PSSI breaking news more accessible than ever. From a future outlook perspective, the potential for Indonesian football is immense . The sheer number of young aspiring footballers, coupled with the nation’s enthusiasm, provides a fertile ground for talent discovery and development. PSSI’s long-term strategies are increasingly focused on grassroots programs, identifying and nurturing talent from a young age, and providing them with the best possible pathway to professional football and the national team. Furthermore, the ongoing professionalization of the leagues, as discussed earlier, is laying a stronger foundation for sustained success. We can expect more PSSI breaking news related to international collaborations, such as partnerships with foreign federations for knowledge exchange and development programs. The aim is to learn from global best practices and adapt them to the Indonesian context. The challenges are significant, but the determination to elevate Indonesian football to new heights is palpable. Following PSSI breaking news is your window into this dynamic journey of progress, resilience, and ambition. The association is charting a course towards a brighter future, marked by professionalism, integrity, and widespread success on both domestic and international fronts. The path forward requires continued dedication, strategic investment, and the unwavering support of the football community. We’re optimistic about what the future holds, and we’ll be here to keep you informed every step of the way regarding all the latest PSSI breaking news and developments.